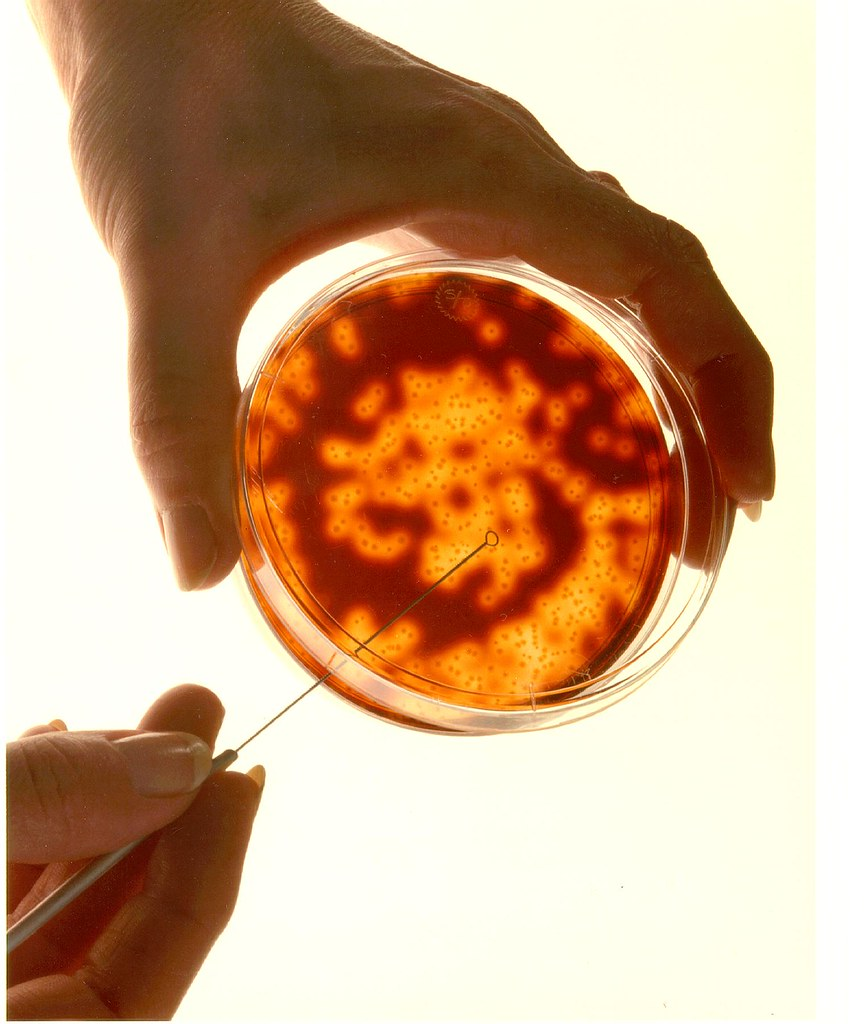

Theoretical vs Applied Physicist/ Christian
Confession: I used to be an addict to the TV series the big bang theory.
Note: I do NOT recommend this sitcom or anything similar to it. They can puncture our values and belief system drastically.
The two main characters in this series are a theoretical physicist & an applied physicist. I asked myself, what does a theoretical physicist do, and how is it different from the work of an applied physicist?
In simple terms, a theoretical physicist works completely in a lab, a highly controlled environment, and relies heavily on data, empirical formulae while trying to push the boundaries of science. In short, everything is done inside a petri dish.
An applied physicist, on the other hand, lives closer to the real world. His job is to bring, what is experimented in the lab feasible in the real world, again using experiments. It’s the engineers(workmen trained in applied science) who make it as a useful product for the layman.
I realized that this can be an analogy to the life of a disciple of Christ. I can be a theoretical believer or an applied believer. Let me explain -
As a theoretical believer, I can read the Bible several times, shoot Bible trivia questions faster than an automatic gun, read extensively the classic works of the puritans and the contemporary work of the reformed authors, attend several camps in a year, share the gospel and distribute tracts on the beach, park, and bus, go on several mission trips, fasting & prayers, etc., etc., and yet be just a head-knowledge, trying to ‘do’ the right things Christian. It can mean nothing.
Please don’t mistake me that I am undervaluing any of the experiences that I quoted above. I have done all this and yet seen pride take over, over and over again in my life. I struggle to love my neighbor who parks his car inconveniently for me. I am not able to show joy at even the slightest of bad news, sometimes even when I am just moody! Forgiving before the sun going down is hard because sometimes I harbor wrong done to me for a few months. My words are not graceful, my motives are wrong and I do not want to surrender the throne of my heart to Christ.
If all my learning, reading, etc is only for my head knowledge and I am not able to put it into practice, I desperately need the Holy Spirit to help me obey the commands of God.
I don’t want to be a Christian in a petri dish.

Comments
Post a Comment